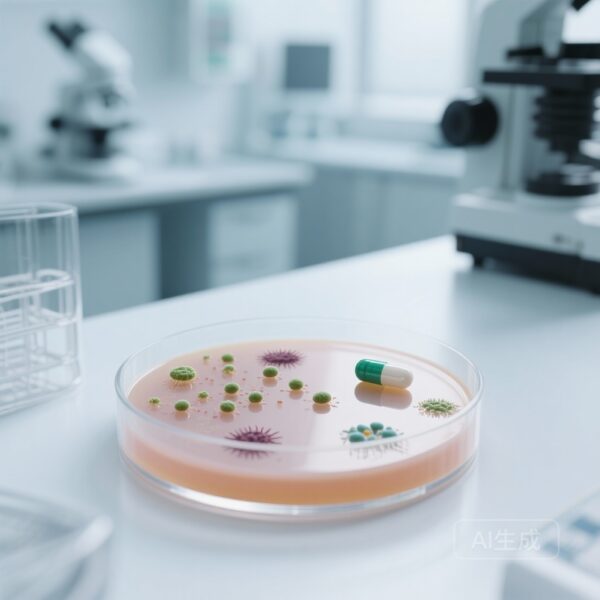
Oral Zoliflodacin Proves Non-Inferior to Standard Dual Therapy for Gonorrhoea: A Milestone in Antimicrobial Resistance Management

Highlights
- Lower respiratory infections (LRIs) resulted in 2.50 million deaths and 98.7 million DALYs globally in 2023, remaining the leading infectious cause of mortality.
- Mortality among children younger than 5 years decreased by 33.4% since 2010, yet 129 of 204 countries have met the GAPPD target of fewer than 60 deaths per 100,000.
- Streptococcus pneumoniae remains the leading LRI pathogen, responsible for 25.3% of all LRI deaths.
- The inclusion of 11 newly modelled pathogens, including non-tuberculous mycobacteria and Aspergillus spp, accounts for approximately 22% of the global LRI death toll.
The Enduring Challenge of Lower Respiratory Infections
Lower respiratory infections (LRIs), primarily manifesting as pneumonia and bronchiolitis, continue to represent a formidable challenge to global health security. Despite decades of intervention through expanded vaccination programs and improved access to antibiotics, LRIs remain the world’s leading infectious cause of death. The Global Burden of Diseases, Injuries, and Risk Factors Study (GBD) 2023 provides a critical update on the landscape of LRI mortality and morbidity, offering a granular view of 26 pathogens across 204 countries and territories from 1990 to 2023.
This latest analysis is particularly significant as it introduces 11 newly modelled pathogens and assesses global progress toward the 2025 Global Action Plan for the Prevention and Control of Pneumonia and Diarrhoea (GAPPD) targets. As the world transitions out of the acute phase of the COVID-19 pandemic, understanding the baseline burden of endemic respiratory pathogens is essential for prioritizing public health resources and clinical research.
Study Design and Methodological Advancements
The GBD 2023 study utilized the Cause of Death Ensemble model (CODEm), integrating data from vital registration systems, verbal autopsies, surveillance programs, and minimally invasive tissue sampling. To estimate morbidity, the researchers employed DisMod-MR 2.1, a Bayesian meta-regression tool, to ensure consistency across incidence and prevalence data. A significant methodological leap in this iteration was the use of splined binomial regression to model pathogen-specific case-fatality ratios (CFRs), providing internally consistent estimates of mortality proportions attributable to viral, bacterial, fungal, and parasitic agents.
The study specifically focused on Disability-Adjusted Life-Years (DALYs), calculated as the sum of Years of Life Lost (YLLs) and Years Lived with Disability (YLDs). Progress was measured against the GAPPD target: a mortality rate of less than 3 deaths per 1,000 livebirths for children under five, which translates to roughly 60 deaths per 100,000 children.
Global Burden and Demographic Disparities
In 2023, LRIs were responsible for 2.50 million deaths (95% UI 2.24–2.81) and 98.7 million DALYs. The burden follows a distinct U-shaped distribution across the lifespan, with the highest impact observed in children younger than 5 years and adults aged 70 years and older. While the total number of deaths remains staggering, the data reveal a positive trend in pediatric survival. Since 2010, LRI mortality in children under five has fallen by 33.4%.
However, this progress is not uniform. Sub-Saharan Africa continues to bear a disproportionate share of the burden, with mortality rates in children under five remaining the furthest from the GAPPD targets. In contrast, the burden among the elderly (70+ years) has seen only marginal declines. As the global population ages, the relative contribution of older adults to the total LRI burden is expected to increase, presenting a dual challenge for health systems that must sustain pediatric gains while addressing the rising vulnerability of the geriatric population.
The Pathogen Landscape: Old Rivals and New Threats
The GBD 2023 analysis offers a comprehensive breakdown of the aetiologies driving LRI mortality.
Streptococcus pneumoniae
remains the most lethal pathogen, accounting for 634,000 deaths (25.3% of all LRI deaths). This underscores the continued need for high coverage of pneumococcal conjugate vaccines (PCV), particularly in low-income settings where access remains suboptimal.
Other major bacterial contributors include
Staphylococcus aureus
(271,000 deaths) and
Klebsiella pneumoniae
(228,000 deaths). These pathogens are of particular concern due to their association with antimicrobial resistance (AMR), which complicates treatment and increases the risk of mortality in hospital settings.
A landmark feature of the 2023 study is the inclusion of 11 newly modelled pathogens. These emerging or previously under-recognized aetiologies, including non-tuberculous mycobacteria (NTM) and Aspergillus spp, accounted for 22% of LRI deaths. NTM alone was responsible for 177,000 deaths, while Aspergillus spp contributed to 67,800 deaths. The identification of these pathogens as significant contributors to LRI mortality suggests a need for expanded diagnostic capabilities and targeted therapeutic strategies beyond traditional pneumonia protocols.
Expert Commentary: Bridging the Gap in Care
The findings of the GBD 2023 study highlight a critical intersection between epidemiology and health policy. Clinical experts note that while the reduction in pediatric mortality is a triumph of vaccination and nutritional interventions, the stagnation in older adult mortality and the persistent gap in sub-Saharan Africa indicate systemic failures in healthcare equity.
The emergence of NTM and fungal pathogens like Aspergillus as major killers suggests that our current clinical focus may be too narrow. In many high-burden regions, diagnostic tools are limited to sputum microscopy or basic radiology, which are insufficient for identifying these complex aetiologies. Furthermore, the rise of respiratory syncytial virus (RSV) as a major driver of pediatric hospitalizations calls for the rapid deployment of newer interventions, such as long-acting monoclonal antibodies (e.g., nirsevimab) and maternal immunization.
From a policy perspective, the fact that only 129 of 204 countries have met the GAPPD target indicates that the ‘last mile’ of pneumonia control will be the hardest. It requires not just vaccines, but also the strengthening of primary healthcare systems to ensure early diagnosis and the availability of therapeutic oxygen and appropriate antibiotics.
Conclusion and Future Directions
The GBD 2023 analysis serves as both a scorecard for past efforts and a roadmap for future interventions. The significant decline in child mortality proves that targeted public health strategies work. However, the high burden of LRIs in sub-Saharan Africa and the increasing vulnerability of the elderly population demand a recalibration of global health priorities. To achieve the GAPPD targets and reduce the global toll of LRIs, the international community must focus on equitable vaccine distribution, the development of diagnostics for emerging pathogens, and the integration of adult immunization programs into routine care.
Funding
This study was funded by the Bill & Melinda Gates Foundation.
References
- GBD 2023 Lower Respiratory Infections and Antimicrobial Resistance Collaborators. Global burden of lower respiratory infections and aetiologies, 1990-2023: a systematic analysis for the Global Burden of Disease Study 2023. Lancet Infect Dis. 2025 Dec 15. doi: 10.1016/S1473-3099(25)00689-9.
- UNICEF/WHO. Global Action Plan for the Prevention and Control of Pneumonia and Diarrhoea (GAPPD). 2013.
- Kyu HH, et al. Causes of death among children under 5 years in the GBD 2021 study. Lancet. 2024.